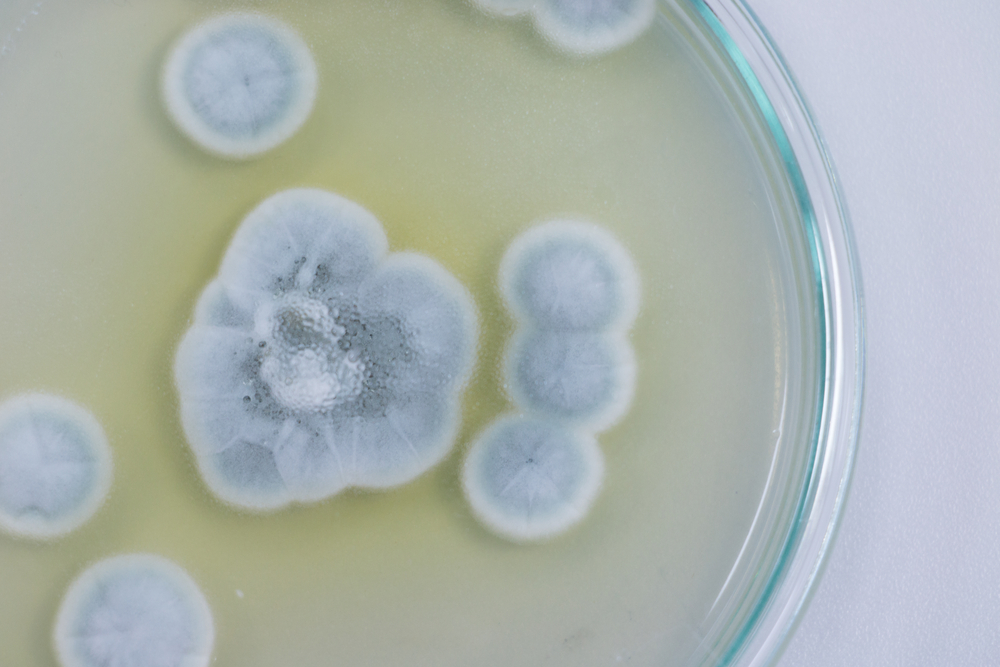

Дерматомикозами называют обширную группу инфекционных поражений кожи, которые провоцируются различными видами патогенных грибков-дерматофитов. Эти заболевания могут наблюдаться и у взрослых, и у детей, но некоторые из них чаще наблюдаются у определенной возрастной категории. Такая особенность связана с тем, что у разных возрастных групп наблюдаются отличия в характере потоотделения, составе пота, кожного жира и их уровне рН.
В нашей статье мы ознакомим вас с основными разновидностями дерматомикозов, причинами их развития, способами диагностики, лечения и профилактики. Эти знания будут полезны для вас, и вы сможете вовремя заподозрить развитие болезни и совместно с врачом принять необходимые меры. Помните о том, что заниматься самолечением дерматомикозов нельзя, т. к. подобрать необходимый противогрибковый препарат можно только после проведения анализа, который поможет определить вид грибка-возбудителя. При ошибочном выборе того или иного антимикотического средства лечение может быть непродуктивным, заболевание будет усугубляться и станет хроническим.
Причины
Возбудителями дерматомикозов являются грибки-дерматофиты:
- Microsporum;
- Epidermophyton (некоторые виды);
- Trichophyton.
В редких случаях дерматомикозы провоцируются различными видами грибков из рода Candida.
Большинство дерматофитов более интенсивно размножаются во влажной нейтральной или щелочной среде при температуре, приближенной к температуре человеческого тела (20-30 °C). Именно поэтому частота заболеваемости дерматомикозами существенно увеличивается в теплое время года.
Среди дерматофитов выделяют такие разновидности грибков:
- антропофильные – паразиты человека;
- зоофильные – паразиты животных;
- геофильные – паразиты, обитающие в почве.
На кожу, волосы или ногти человека попадают споры, кондии или гифы этих грибков и, при наличии благоприятных условий, инфицируют ее. После заражения начинается разрушение пораженного участка эпидермиса, т. к. эти возбудители питаются кератином.
Заражение дерматофитами происходит при непосредственном контакте человека с:
- больным;
- инфицированным животным (кошкой, собакой);
- инфицированными объектами (обувь, полотенца, пол ванной комнаты или бани, ковры и др.).
После контакта здорового человека с дерматофитами заболевание наступает не всегда. Риск развития этих поражений кожи повышается при таких состояниях:
- снижение иммунитета;
- эндокринные заболевания;
- нарушения целостности кожных покровов;
- потливость;
- нарушения обмена веществ;
- нерациональное питание (авитаминозы и гиповитаминозы).
Классификация
Дерматомикозы классифицируются по месту локализации:
- гладкой кожи тела;
- волосистой части головы и бороды;
- ногтей;
- паховой области;
- стоп.
В зависимости от возбудителя дерматомикозы классифицируют на:
- кератомикозы: узловатая микроспория, разноцветный лишай;
- дерматофитии: паховая эпидермофития, эпидермофития стоп, трихофития, черепитчатый микоз, фавус, руброфития;
- глубокие микозы: аспергиллез, хромомикоз, бластомикоз, споротрихоз и др.;
- кандидоз: поверхностный, висцеральный и хронический генерализованный;
- псевдомикозы: актиномикоз, трихомикоз, эритраза и др.
Симптомы

Выраженность клинических признаков при дерматомикозах зависит от формы и длительности заболевания.
Дерматомикоз гладкой кожи тела
Это поражение кожи вызывается грибком трихофитоном и чаще наблюдается в странах с теплым климатом. При дерматомикозе гладкой кожи на любом участке кожных покровов тела могут обнаруживаться такие признаки:
- розовая или красная сыпь, образующая округлые пятна;
- в центре очага появляется участок просветления;
- влажные участки сыпи покрываются корочками;
- края округлого очага покрываются чешуйками, начинают зудеть и шелушиться;
- центр очага очищается, и на коже остается след в виде круга.
При вторичном бактериальном инфицировании очаг сыпи может рубцеваться и оставлять на коже участок с гиперпигментацией.
Дерматомикозы волосистой части головы и бороды
Это заболевание чаще наблюдается у детей и провоцируется грибком микроспорумом или трихофитоном.
В области волосистой части головы наблюдаются такие симптомы:
- появление папулезной сыпи и ее распространение;
- в области сыпи на коже образуются фурункулообразные узлы;
- кожа становится красной, зудит, болит и начинает шелушиться;
- волосы в очагах поражения становятся ломкими и выпадают из-за гнойного расплавления волосяных фолликулов.
При поражении грибком области бороды или усов наблюдаются такие симптомы:
- под волосяным покровом лица появляются пузырьки (папулы и пустулы);
- волосяные фолликулы воспаляются и нагнаиваются из-за вторичного бактериального инфицирования;
- кожа в очаге поражения становится отечной, болезненной и покрывается кровяными корками.
Такие дерматомикозы очень заразны, и больной должен незамедлительно обратиться за врачебной помощью.
Дерматомикоз ногтей

Поражение ногтевых пластин грибком (или онихомикоз) вызывается грибком трихофитоном, который внедряется в зону роста ногтя. У больного появляются такие симптомы:
- утолщение, изменение оттенка и деформация ногтевой пластины;
- скопление под ногтем отмерших клеток;
- отслоение и разрушение ногтя.
Чаще грибковое поражение ногтей наблюдается на пальцах ног, реже – рук.
Дерматомикоз паховой области
Это заболевание может провоцироваться различными грибками: Trichophyton rubrum, Epidermophyton floccosum, Trichophyton mentagrophytes и Candida. У больного появляются такие симптомы:
- на коже в области паховых складок появляются розовые округлые пятна с нечеткими очертаниями, которые в дальнейшем могут распространяться на поверхность бедер, область ануса и промежность;
- при самозаражении такие же пятна могут появляться в складках под молочными железами и других частях тела;
- пятна увеличиваются в размерах и могут сливаться;
- по краю пораженного очага образуются пузырьки, которые зудят, вызывают ощущение жжения и боли, лопаются, покрываются корочками и чешуйками;
- после вскрытия пузырьки могут вторично инфицироваться, и у больного развиваются нагноения кожи (пиодермия);
- пораженная кожа начинает шелушиться, и воспаление постепенно пропадает (особенно если была устранена повышенная влажность пораженной области).
Возбудители могут длительное время оставаться на коже, они вызывают развитие рецидивов пахового дерматомикоза.
Паховый дерматомикоз чаще наблюдается у больных сахарным диабетом и мужчин, страдающих от ожирения. Заболевание может провоцироваться ношением тесной одежды и частой повышенной влажностью в области паха. Заражение может происходить при контакте с больным и через бытовые предметы (постельное белье, полотенца, сидения унитазов, спортивный инвентарь и пр.).
Дерматомикоз стоп
Это заболевание провоцируется трихофитом или эпидермофитоном. Дерматомикоз стоп может протекать в скваматозной, интертригинозной или дисгидротической форме.
При скваматозной форме у больного появляются такие симптомы:
- вначале поражается кожа в межпальцевых складках ног;
- на коже появляются шелушения, которые не сопровождаются другими ощущениями;
- иногда, шелушения более выражены, сопровождаются повелением пузырьков или высыпаний мокнущего характера и зудом;
- область поражения может вторично инфицироваться и нагнаиваться;
- со временем область шелушения распространяется на боковые поверхности стоп;
- очаги поражения сливаются и покрываются чешуйками светлого цвета;
- у больного появляется шелушение, сухость, болезненность и зуд стоп.
При интертригинозной форме у больного в области межпальцевых пространств появляются такие симптомы:
- трещины;
- краснота;
- отечность;
- мокнущие эрозии.
При дисгидротической форме у больного в области межпальцевых пространств появляются такие симптомы:
- многочисленные пузырьки в области подошв, сводов стоп и пальцев;
- пузырьки лопаются и появляются эрозии.
Наиболее часто дерматомикоз стоп наблюдается у молодых мужчин. Дерматологами был отмечен и тот факт, что у молодых пациентов чаще выявляется микоз, сопровождающийся воспалением и мокнутием, а у пожилых – «сухой». Дерматомикозы стоп часто обостряются, осложняются вторичным инфицированием и характеризуются длительным и многолетним течением.
Диагностика
Симптомы дерматомикозов могут быть сходны с другими болезнями кожи (псориаз, экзема) и для назначения адекватной терапии необходимо точно определить вид возбудителя, который вызвал заболевания. Именно поэтому всем больным, которые выявили у себя признаки таких поражений кожи, необходимо обратиться к врачу-дерматологу (или микологу), который сможет точно установить диагноз и составить схему дальнейшего лечения. До визита к врачу нельзя смазывать пораженные участки кожи антисептическими растворами (йодом, зеленкой, перекисью водорода и т. п.) или мазями, т. к. их применение может стать причиной неправильной диагностики.
Для проведения лабораторных анализов врач проведет забор материала, которым могут стать:
- соскобы кожи (корочки или чешуйки с пораженных участков);
- волосы;
- ногти.
Полученный материал исследуется под микроскопом сразу после забора или после посева на питательные среды. Благодаря этим исследованиям врач может точно установить тип возбудителя-грибка и назначить эффективное лечение.
Для диагностики дерматомикозов могут применяться и такие методики:
- дермоскопия;
- анализ крови на выявление антител к грибкам.
Лечение

Тактика лечения дерматомикозов должна подбираться индивидуально для каждого больного. Врач-дерматолог учитывает такие факторы:
- тип грибка-возбудителя;
- течение заболевания;
- возраст;
- общее состояние здоровья.
Основным способом лечения дерматомикозов является назначение противогрибковых средств для наружного или внутреннего применения. Без применения таких препаратов достичь выздоровления больного невозможно.
Современная фармакологическая индустрия выпускает около 200 наименований противогрибковых средств, но подобрать одно из них можно только после проведения лабораторных анализов, которые определят тип возбудителя дерматомикоза. На начальных стадиях заболевания врач может ограничиться назначением противомикотических препаратов для наружного применения, но при запущенных случаях в схему терапии могут включаться таблетированные формы для приема внутрь. Их дозирование и длительность приема также определяются строго индивидуально.
При необходимости в схему лечения могут включаться антибиотики и гормональные средства для местного или внутреннего применения. Для обработки мокнущих участков кожи применяются антисептические растворы (борной кислоты, марганцовки, хлоргексидина), а для устранения значительных участков ороговения – кератолитические препараты.
В схему лечения дерматомикозов обязательно включаются иммунодуляторы, витаминные препараты и средства для ускорения заживления поврежденных участков кожи.
При выявлении дерматомикоза врач обязательно знакомит больного с методами дезинфекции предметов быта, одежды или обуви и дает рекомендации по предупреждению распространения инфекции.
Профилактика
Грибки-дерматофиты размножаются во влажной и теплой среде, и поэтому лучшей мерой профилактики этих поражений кожи станет содержание тела в чистоте и сухости. Предупредить развитие этих грибковых заболеваний поможет соблюдение таких простых правил:
- Поддерживать свой иммунитет и правильно питаться.
- Не ходить босиком в общественных местах.
- Не надевать чужую обувь или одежду.
- Не пользоваться чужими полотенцами.
- Содержать обувь и одежду в чистоте.
- Носить одежду из натуральных тканей.
- Избегать ношения облегающей одежды из синтетических тканей (особенно в теплое время года).
- Никогда не пользоваться чужими маникюрными принадлежностями, расческами, заколками или резинками для волос.
- Не гладить бродячих и незнакомых животных.
- Следить за здоровьем домашних питомцев и регулярно осматривать их шерсть и кожу на наличие грибковых поражений.
Помните о том, что при появлении первых признаков дерматомикозов необходимо сразу обратиться к дерматологу!
Только врач сможет назначить эффективное лечение, и вы сможете навсегда избавиться от этих неприятных заболеваний. Будьте здоровы!
К какому врачу обратиться
При появлении зуда и шелушения кожи на любом участке тела необходимо обратиться к дерматологу. После диагностики пациент может быть направлен к микологу — специалисту по грибковым заболеваниям.
Довольно часто микозы возникают на фоне сопутствующих заболеваний (сахарного диабета, ожирения) и иммунодефицита. Поэтому иногда возникает необходимость консультации эндокринолога, иммунолога и инфекциониста. Для более точной дифференциальной диагностики микозов и аллергических поражений кожи требуется осмотр аллерголога.
